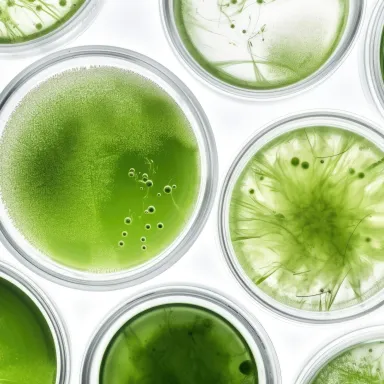

Filters
- Ingredients
- Finished Products
- Delivery Formats
- Operations Management and Services

Clear whey protein sodaArla Foods Ingredients

Reducose®Phynova

100 500 DPA ALGAE SENSORYPolaris

UbiOmega®Vita Actives Limited

spermidineLIFE® Pro+TLL The Longevity Labs GmbH

Zensera™Givaudan International SA

L. gasseri CP2305 postbioticADM International Sàrl

Fibalance™ PHGG(Partially Hydrolyzed Guar Gum)Zymebase Inc.

cellflo6®PLT Health Solutions

NOW® EnergyPlanttech Biotechnology Spain S.L,

LactoBeet™Sabinsa Europe GmbH

ProSinensisSKYHERB

Kūlaris™Vidya Herbs PVT Ltd

SpectramunePLT Health Solutions

Ebel.One™ Preactivated Bacopa ConcentrateIMCD ESPAA ESPECIALIDADES QUIMICAS SA

novaPROX comboProbionova SA

Safr’Inside™ for SleepActiv'Inside

perFix™Euromed

Mindrevive®Monteloeder / Gonmisol by Suannutra

Chondractiv™ MoveSymrise

Tulsinity®LABORATOIRES EXPANSCIENCE

Somin-OnArjuna Natural Pvt Ltd

PhytoCellTec™ Md NuMibelle Biochemistry

OVOLUXStratum Nutrition

Biotis® LactoferrinFrieslandCampina Nederland BV

Xelflex®INGREDIA SA

DracoBelle™ Nu sdMibelle Biochemistry

PollenBerry®Graminex LLC

OkraviveArjuna Natural Pvt Ltd

AKK001Nutraland USA Inc

SYMBALM™Groupe Berkem

Bovine Collagen TripeptideWeishardt International

B2Bioticdsm-firmenich

UC-II® PetsLonza Capsules & Health Ingredients

Biolane™ – Green-lipped Mussel ExtractAroma New Zealand Ltd

SPF VET’PALSymrise

Silactive®Euromed

LeciFIT Berry (High Value Fructolecithin Granuels)FISMER LECITHIN GmbH

Witholytin® AhwagandhaLEHVOSS Nutrition

N-utraNutriearth

OMEGA-3H 5436TGNHUATAI BIOPHARM INC.

IMWITOR ® 375IOI Oleo GmbH
EGGCAL-ESM (Water Soluble)Caltron Clays & Chemicals Pvt. Ltd.